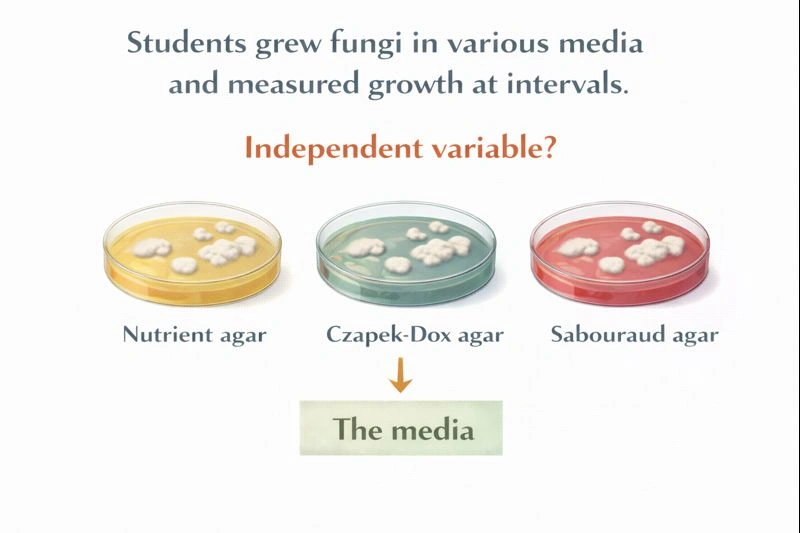
Students grew fungi in various media and measured growth at intervals. What was the independent variable?

BIOLOGY HESI A2 PRACTICE TEST
This Biology HESI A2 Practice Test is designed to assess your understanding of the core biological principles tested on the HESI A2 exam. The quiz mirrors the structure and difficulty level of real exam questions, helping you evaluate your readiness in areas such as cells, genetics, evolution, and human biology. Each question includes a detailed explanation to strengthen your understanding and reinforce key concepts commonly tested on the exam.
Topics Covered
Cell Biology
Genetics
Evolution
Biological Molecules
Energy in Living Systems
Human Biology
00:00
Which is an end product of digestion of carbohydrates?
A.
Amino acids
B. Glucose
C. Fatty acids
D. Glycerol
Rationale
Glucose is an end product of digestion of carbohydrates.
Carbohydrates are digested into simple sugars that the body can absorb and use for energy. During digestion, complex carbohydrates such as starches and disaccharides are broken down step by step into monosaccharides. The most important and final absorbable product of carbohydrate digestion is glucose, which enters the bloodstream and serves as a primary energy source for cells.
A) Amino acids
Amino acids are the end products of protein digestion, not carbohydrate digestion. Proteins are broken down by proteases and peptidases into individual amino acids, which are then absorbed in the small intestine. Carbohydrates do not contain amino groups or peptide bonds, so amino acids cannot result from carbohydrate digestion.
B) Glucose
This is the correct answer. Carbohydrate digestion begins in the mouth with salivary amylase and continues in the small intestine with pancreatic amylase, which break down starch into smaller sugars such as maltose and maltotriose. Brush border enzymes in the small intestine (maltase, sucrase, and lactase) then convert these disaccharides into monosaccharides. Glucose is the primary and universal monosaccharide produced and absorbed. It is transported into intestinal cells via sodium-glucose transporters and then released into the bloodstream to be used for energy or stored as glycogen.
C) Fatty acids
Fatty acids are produced during lipid digestion, not carbohydrate digestion. Lipases break triglycerides into fatty acids and glycerol. Since carbohydrates do not contain fatty acid chains, fatty acids cannot be an end product of carbohydrate digestion.
D) Glycerol
Glycerol is also a product of fat digestion and forms the backbone of triglycerides. It is released when lipids are broken down by lipases. Carbohydrates do not contain glycerol, so this option is incorrect.
Conclusion
The digestion of carbohydrates ultimately produces monosaccharides, with glucose being the most important and widely absorbed end product. Therefore, the correct answer is B) Glucose.

Which animal breeds by internal fertilization but external development?
A.
Fox
B. Seahorse
C. Sparrow
D. Earthworm
Rationale
The animal that breeds by internal fertilization but external development is the sparrow.
In this reproductive pattern, fertilization occurs inside the female's body, but the embryo develops outside the mother after eggs are laid. This combination is typical of birds and distinguishes them from mammals (internal fertilization and internal development) and many aquatic animals (external fertilization).
A) Fox
Foxes are mammals. They reproduce through internal fertilization and internal development. After fertilization, the embryo develops inside the uterus, supported by the placenta, until live birth occurs. Because development is internal, this option does not fit the description.
B) Seahorse
Seahorses do involve internal fertilization, but the development is not truly external. After fertilization, the female deposits eggs into the male's brood pouch, where the embryos develop in a protected internal environment until birth. Since development still occurs within a body structure, this does not qualify as external development.
C) Sparrow
This is the correct answer. Sparrows are birds, and birds reproduce through internal fertilization during mating. After fertilization, the female lays shelled eggs. The embryos then develop outside the mother's body within the egg, relying on yolk for nourishment. This is the classic example of internal fertilization followed by external development.
D) Earthworm
Earthworms do not meet the fertilization requirement. Although earthworms exchange sperm internally, actual fertilization occurs outside the body within a cocoon secreted by the clitellum. Because fertilization itself is external, this option does not satisfy the condition of internal fertilization.
Conclusion
Internal fertilization combined with external development is characteristic of birds. The sparrow fits this pattern precisely, making C) Sparrow the correct answer.

What kind of symbiosis exists between a pneumonia bacterium and a human?
A.
Mutualism
B. Parasitism
C. Commensalism
D. Competition
Rationale
The relationship between a pneumonia-causing bacterium and a human is parasitism.
In this interaction, one organism benefits while the other is harmed. Pneumonia bacteria invade human tissues, use the host's resources to survive and reproduce, and in doing so cause illness. This fits the biological definition of parasitism.
A) Mutualism
Mutualism describes a relationship in which both organisms benefit. This does not apply here because the human host does not gain any benefit from infection. Instead, the human experiences inflammation, impaired lung function, and potentially life-threatening complications. Since only one organism benefits, this option is incorrect.
B) Parasitism
This is the correct answer. In parasitism, the parasite benefits at the expense of the host. Pneumonia-causing bacteria such as Streptococcus pneumoniae obtain nutrients and a protected environment within the human body. The host, meanwhile, is harmed through tissue damage, immune responses, reduced oxygen exchange, and systemic illness. The bacterium's survival and reproduction directly depend on exploiting the host, which defines a parasitic relationship.
C) Commensalism
Commensalism occurs when one organism benefits while the other is neither helped nor harmed. This does not apply because pneumonia clearly harms the human host by causing disease. Therefore, this option is incorrect.
D) Competition
Competition involves two organisms attempting to use the same limited resource, typically within the same environment. While bacteria and humans interact within the body, the relationship is not one of equal competition but of exploitation. The bacterium relies on the host for survival rather than competing with it as a separate organism for external resources.
Conclusion
A pneumonia bacterium benefits by living and reproducing inside the human body, while the human host is harmed by disease and tissue damage. This one-sided benefit with host harm defines parasitism. Therefore, the correct answer is B) Parasitism.

Students grew fungi in various media and measured growth at intervals. What was the independent variable?
A.
The fungi
B. The measurements
C. The media
D. The number of weeks
Rationale
Intentionally varied by the investigators -> this is what changes -> definition of The independent variable was the type of media used to grow the fungi.
In an experiment, the independent variable is the factor that the researchers deliberately change in order to observe its effect on the outcome. In this study, the students intentionally grew fungi in different media to see how growth would vary, making the media the manipulated factor.
A) The fungi
The fungi are the organisms being studied. They are the subjects of the experiment, not something the researchers are changing. Because the fungi remain the same while conditions are altered, they are not the independent variable.
B) The measurements
The measurements of fungal growth represent the results of the experiment. These measurements depend on the conditions provided and therefore are the dependent variable, not the independent variable.
C) The media
This is the correct answer. The students intentionally changed the type of growth media to observe how it affected fungal growth. Since this is the factor being manipulated by the experimenters, it meets the definition of an independent variable.
D) The number of weeks
Time is a controlled aspect of the experiment. Measuring growth at intervals allows for comparison, but time itself is not the factor being tested. It is a constant framework rather than the variable being manipulated.
Conclusion
The independent variable is the factor deliberately changed by the researchers. In this experiment, that factor was the type of media used to grow the fungi. Therefore, the correct answer is C) The media.
Which is a by product of fermentation in muscle cells?
A.
Ethanol
B. Pyruvic acid
C. Lactic acid
D. Oxygen
Rationale
Lactic acid is the by-product of fermentation in muscle cells.
When muscle cells are deprived of sufficient oxygen during intense activity, they switch from aerobic respiration to anaerobic metabolism. In this situation, glycolysis continues to produce ATP, but it requires a way to regenerate NAD+ from NADH. Muscle cells achieve this through lactic acid fermentation, in which pyruvate is converted into lactic acid. This allows glycolysis to continue supplying energy, even without oxygen.
A) Ethanol
Ethanol is not produced in human muscle cells. Ethanol fermentation occurs in yeast and some plants, where pyruvate is converted into ethanol and carbon dioxide. Human cells lack the enzymes required for ethanol fermentation, so this option is incorrect.
B) Pyruvic acid
Pyruvic acid is not a by-product of fermentation; it is the molecule that enters fermentation. During glycolysis, glucose is broken down into pyruvate. In anaerobic conditions, pyruvate is then converted into lactic acid. Because pyruvic acid is the starting substrate rather than the end product, this option is incorrect.
C) Lactic acid
This is the correct answer. In muscle cells, lactic acid fermentation occurs when oxygen is limited. The enzyme lactate dehydrogenase reduces pyruvate to lactic acid (lactate), simultaneously oxidizing NADH back to NAD+. This regeneration of NAD+ is essential for glycolysis to continue producing ATP. The accumulation of lactic acid is associated with muscle fatigue during intense exercise.
D) Oxygen
Oxygen is not produced during fermentation. Fermentation is an anaerobic process, meaning it occurs in the absence of oxygen. Oxygen is used in aerobic respiration, not generated during fermentation. Therefore, this option is incorrect.
Conclusion
In muscle cells undergoing anaerobic respiration, pyruvate is converted into lactic acid to allow continued ATP production through glycolysis. Therefore, the correct answer is C) Lactic acid.

Flagella and cilia are typically used for which life process?
A.
Excretion
B. Nutrition
C. Respiration
D. Movement
Rationale
Movement is the life process typically carried out by flagella and cilia.
Flagella and cilia are specialized cellular structures designed to produce motion. Their coordinated beating or whipping action allows cells to move through their environment or to move substances along the surface of cells. This function is fundamental to locomotion and transport rather than metabolism or exchange processes.
A) Excretion
Excretion involves the removal of metabolic waste products from the cell or organism, usually through diffusion, active transport, or specialized organs such as kidneys. Flagella and cilia do not function in waste removal and are not involved in excretory pathways.
B) Nutrition
While cilia can assist in moving food particles toward feeding structures in some organisms (such as cilia lining the gills of aquatic animals or the oral groove of protozoans), this is a secondary role. Their primary and defining function is movement, not nutrient acquisition or digestion.
C) Respiration
Respiration refers to gas exchange (oxygen and carbon dioxide) and cellular energy release. Gas exchange occurs across membranes or specialized respiratory surfaces, not through the mechanical beating of flagella or cilia. Therefore, respiration is not their primary role.
D) Movement
This is the correct answer. Flagella and cilia generate movement through the action of motor proteins (dynein) that cause microtubules within these structures to slide against one another. This produces bending motions that propel cells, such as sperm cells using flagella, or move fluids across cell surfaces, such as cilia in the respiratory tract moving mucus.
Conclusion
The defining and universal function of flagella and cilia is movement, either of the entire cell or of materials along a cell surface. Therefore, the correct answer is D) Movement.

Which is found in animal cells but not in plant cells?
A.
Centriole
B. Cytoplasm
C. Vacuole
D. Golgi apparatus
Rationale
Centrioles are found in animal cells but not in plant cells.
Animal and plant cells share many common organelles because both are eukaryotic. However, some structures are specific to one group. Centrioles are a distinguishing feature of animal cells and are generally absent in plant cells.
A) Centriole
This is the correct answer. Centrioles are cylindrical structures made of microtubules and are involved in organizing the spindle fibers during cell division. In animal cells, centrioles are part of the centrosome and play a key role in mitosis and meiosis. Most plant cells do not contain centrioles and instead organize spindle fibers using other microtubule-organizing centers.
B) Cytoplasm
Cytoplasm is present in all living cells, including both animal and plant cells. It is the gel-like substance that fills the cell and suspends organelles. Because it is universal, this option is incorrect.
C) Vacuole
Both plant and animal cells have vacuoles. Plant cells typically have a large central vacuole that maintains turgor pressure and stores substances, while animal cells may contain smaller vacuoles or vesicles. Since vacuoles exist in both, this option is incorrect.
D) Golgi apparatus
The Golgi apparatus is found in both animal and plant cells. It modifies, sorts, and packages proteins and lipids for transport within or outside the cell. Because it is common to both cell types, this option is incorrect.
Conclusion
Centrioles are characteristic of animal cells and are generally absent in plant cells. Therefore, the correct answer is A) Centriole.

What happens to glucose during glycolysis?
A.
Its energy is entirely lost
B. It splits into molecules of pyruvic acid
C. It is stored in NADH
D. It joins with citric acid
Rationale
Glucose splits into molecules of pyruvic acid during glycolysis.
Glycolysis is the first major pathway of cellular respiration and occurs in the cytoplasm of the cell. Its central purpose is to break down one six-carbon glucose molecule into two three-carbon molecules, capturing some of the energy released in the form of ATP and NADH. This splitting of glucose is the defining event of glycolysis and prepares the carbon molecules for further energy extraction in later stages of respiration.
A) Its energy is entirely lost
This statement is incorrect. Although some energy from glucose is released as heat, a significant portion is conserved. During glycolysis, energy is captured as a net gain of 2 ATP molecules and 2 NADH molecules. These energy carriers are essential for subsequent steps in cellular respiration. Therefore, glucose's energy is not entirely lost.
B) It splits into molecules of pyruvic acid
This is the correct answer. Glycolysis consists of a series of enzyme-controlled reactions that ultimately cleave one six-carbon glucose molecule into two three-carbon molecules of pyruvic acid (also called pyruvate). This splitting is the key outcome of glycolysis and allows cells to continue extracting energy either aerobically or anaerobically.
C) It is stored in NADH
This option is incorrect. NADH does not store glucose. Instead, NADH is an electron carrier produced during glycolysis when electrons and hydrogen ions are transferred from glucose intermediates. Glucose itself is the molecule being broken down, not stored.
D) It joins with citric acid
This is incorrect. Glucose does not directly combine with citric acid. After glycolysis, pyruvic acid is converted into acetyl-CoA, which then combines with oxaloacetate to form citric acid in the Krebs cycle. Glucose never directly enters this reaction.
Conclusion
The defining event of glycolysis is the splitting of one glucose molecule into two molecules of pyruvic acid while capturing usable energy. Therefore, the correct answer is B) It splits into molecules of pyruvic acid.

Where does percolation take place in the water cycle?
A.
Over the ocean
B. In a cloud
C. Underground
D. In a river
Rationale
Percolation takes place underground.
Percolation is a step in the water cycle that describes the downward movement of water through soil and porous rock layers due to gravity. After precipitation reaches the ground, some water runs off the surface, while some infiltrates the soil. As this infiltrated water continues to move deeper through soil and rock spaces, it recharges underground water stores known as aquifers. This subsurface movement is specifically defined as percolation.
A) Over the ocean
Water movement over the ocean surface is mainly associated with evaporation, where liquid water changes into water vapor due to solar energy. There is no soil or rock structure present to allow downward seepage, so percolation does not occur here.
B) In a cloud
Clouds are the site of condensation and precipitation. Water exists as tiny droplets or ice crystals suspended in the atmosphere, not as liquid moving through a solid medium. Because percolation requires soil or rock, it cannot occur in clouds.
C) Underground
This is the correct answer. Underground environments contain soil, sand, gravel, and porous rock that allow water to move downward through small spaces between particles. This process replenishes groundwater and aquifers and is a critical component of the water cycle.
D) In a river
Rivers involve surface runoff and channel flow. Although water may eventually seep from a river into the ground, the river itself represents surface movement, not the subsurface process defined as percolation.
Conclusion
Percolation is the downward movement of water through soil and rock beneath the Earth's surface. Because this process occurs below ground level, the correct answer is C) Underground.

Researchers tracking changing attitudes toward solar power--most useful tool?
A.
Light meter
B. Questionnaire
C. Road map
D. Solar panel
Rationale
The most useful tool for researchers tracking changing attitudes toward solar power is a questionnaire.
Attitudes, opinions, and perceptions are subjective variables that cannot be measured with physical instruments. To understand how people think or feel about solar power, researchers must collect self-reported data directly from individuals. Questionnaires are specifically designed for this purpose and allow trends in public opinion to be measured and compared over time.
A) Light meter
A light meter measures light intensity or solar irradiance. It is useful for assessing physical properties of sunlight but has no ability to measure human beliefs, opinions, or attitudes. Therefore, it is not appropriate for attitude research.
B) Questionnaire
This is the correct answer. Questionnaires are survey instruments used to collect information about people's opinions, beliefs, preferences, and attitudes. By asking standardized questions to many participants, researchers can quantify attitudes toward solar power and analyze how those attitudes change over time.
C) Road map
A road map provides geographic and navigational information. It has no role in collecting or analyzing social or attitudinal data and is irrelevant to this type of research.
D) Solar panel
A solar panel is a technological device used to convert sunlight into electrical energy. While relevant to solar power production, it does not provide information about public attitudes or perceptions.
Conclusion
Because attitudes are subjective and must be measured through direct responses from people, a questionnaire is the most effective tool for tracking changing attitudes toward solar power. Therefore, the correct answer is B) Questionnaire.

Which is not a raw material needed for cellular respiration?
A.
ADP
B. Phosphate
C. Water
D. Glucose
Rationale
The substance that is not a raw material needed for cellular respiration is water.
Cellular respiration is the process by which cells break down glucose in the presence of oxygen to produce ATP, the cell's usable energy. The raw materials for this process are substances that must be supplied to start and sustain ATP production. While some molecules participate indirectly or are produced along the way, not all are considered required inputs.
A) ADP
ADP is required for cellular respiration because it is the molecule that is phosphorylated to form ATP. Without ADP, ATP synthesis cannot occur. Although ADP is recycled within the cell, it still functions as a necessary reactant in the process.
B) Phosphate
Inorganic phosphate (Pi) is essential for ATP formation. During oxidative phosphorylation, phosphate combines with ADP to form ATP. Because ATP production cannot occur without phosphate, it is considered a required raw material.
C) Water
This is the correct answer. Water is not a required raw material for cellular respiration. Instead, water is primarily produced during the final step of the electron transport chain when oxygen accepts electrons and hydrogen ions. Although small amounts of water may be involved in intermediate reactions, it is not an essential starting input like glucose or oxygen.
D) Glucose
Glucose is the main fuel molecule for cellular respiration. It provides the carbon backbone and high-energy electrons that drive ATP production through glycolysis, the Krebs cycle, and the electron transport chain. Without glucose (or another fuel molecule), respiration cannot proceed.
Conclusion
Cellular respiration requires glucose, ADP, and phosphate as essential inputs for ATP production. Water is mainly a product rather than a necessary raw material. Therefore, the correct answer is C) Water.

Which organism has the least specialized organization?
A.
Earthworm
B. Starfish
C. Spider
D. Sponge
Rationale
The organism with the least specialized organization is the sponge.
In biology, the level of organization refers to how cells are arranged and specialized into tissues, organs, and organ systems. Organisms range from very simple, with only loosely associated cells, to highly complex forms with specialized tissues and integrated organ systems. Among the options given, the sponge represents the simplest level of organization.
A) Earthworm
Earthworms belong to the phylum Annelida and exhibit a high degree of structural and functional specialization. They have true tissues and well-developed organ systems, including a complete digestive tract, a closed circulatory system, excretory organs, and a nervous system. Their bodies are segmented, and each segment contains specialized structures that contribute to coordinated body function. This level of organization is far more complex than the cellular level.
B) Starfish
Starfish are members of the phylum Echinodermata and possess true tissues and organ systems. They have a unique water vascular system used for movement and feeding, a true coelom, and specialized structures such as tube feet. Although they may appear simple externally, internally they show a significant level of organization and specialization.
C) Spider
Spiders are arthropods and among the most structurally specialized invertebrates. They have complex organ systems, including a centralized nervous system, specialized respiratory structures (book lungs), jointed appendages, and advanced sensory organs. Their bodies are highly organized and adapted for predation, making them far from the least specialized.
D) Sponge
This is the correct answer. Sponges belong to the phylum Porifera and are organized only at the cellular level. They lack true tissues, organs, and organ systems. Their bodies consist of loosely associated cells, each performing specific functions, but without coordination into tissues. Processes such as digestion, gas exchange, and waste removal occur at the cellular level through diffusion. Because of this extremely simple body plan, sponges are considered the least specialized organisms among the choices.
Conclusion
Sponges lack true tissues and organs and are organized only at the cellular level, making them the least specialized in terms of biological organization. Therefore, the correct answer is D) Sponge.

Whose efficiency of energy is greater?
A.
Herbivore
B. Carnivore
C. Omnivore
D. Decomposer
Rationale
The efficiency of energy use is greatest in decomposers.
Energy efficiency refers to how effectively an organism converts the energy it consumes into usable energy for growth and metabolism. Different consumer groups vary greatly in this efficiency because of the type of food they consume and how much energy is lost during digestion, respiration, and waste.
A. Herbivore
Herbivores feed directly on plants, which places them at a relatively low trophic level. However, plant material is difficult to digest because much of it is made of cellulose, lignin, and other structural carbohydrates. A large proportion of the energy consumed by herbivores is lost as feces, heat, and metabolic waste. As a result, herbivores typically convert only a small fraction of the energy they consume into body biomass.
B. Carnivore
Carnivores feed on other animals and therefore occupy higher trophic levels. Although animal tissue is easier to digest than plant tissue, carnivores receive much less total energy because energy has already been lost at previous trophic levels. Energy transfer from plants to herbivores and then to carnivores follows the ecological efficiency rule, where only a small percentage of energy is passed on at each step. This makes carnivores less efficient overall.
C. Omnivore
Omnivores feed on both plants and animals, allowing flexibility in diet. While this can be advantageous for survival, it does not make omnivores the most energy-efficient group. They are still subject to energy losses from digestion, respiration, and trophic transfer, and their efficiency does not exceed that of decomposers.
D. Decomposer
Decomposers are the most energy-efficient. They break down dead organic matter and waste from all trophic levels, accessing energy that other consumers cannot use. Decomposers digest food externally and absorb simple molecules directly, which allows for very high assimilation efficiency. Because they operate at ambient temperatures and recycle material that would otherwise be lost, they capture and use energy more efficiently than other consumers.
Conclusion: Decomposers have the greatest efficiency of energy use because they recycle organic matter from all trophic levels and lose relatively little energy during digestion and metabolism. Therefore, the correct answer is D. Decomposer.

Students believed salt water would harm hydra locomotion. They placed 100 hydra in 10 % salt water and observed for a week. What was missing?
A.
Control
B. Hypothesis
C. Observation
D. Measurement
Rationale
The experiment was missing a control.
To properly test whether salt water harms hydra locomotion, the students needed a basis for comparison. In experimental design, this is provided by a control group. A control group is kept under normal conditions and does not receive the experimental treatment. Without it, the effect of the independent variable cannot be isolated, and no valid cause-and-effect conclusion can be made.
A. Control
This is the correct answer. The students placed all 100 hydra in 10% salt water, which means every organism was exposed to the experimental condition. They did not keep a separate group of hydra in normal freshwater as a comparison. Without observing how hydra move under normal conditions during the same time period, it is impossible to know whether any change in locomotion was caused by salt water or by other factors such as aging, stress, handling, or lack of food. A control group is essential to establish a baseline and determine whether the treatment truly caused an effect.
B. Hypothesis
This is incorrect. The hypothesis was clearly stated: the students believed salt water would harm hydra locomotion. Having a testable prediction means the hypothesis step was already present.
C. Observation
This is incorrect. The students observed the hydra for a week, which means the observation step was included in the investigation.
D. Measurement
This is incorrect. Although the question does not specify numerical data, observing locomotion implies that movement was being assessed in some way, either qualitatively or quantitatively. The main flaw in the experiment is not measurement, but the lack of a comparison group.
Conclusion: A valid experiment requires a control group to compare results against normal conditions. Because the students tested only hydra in salt water and had no freshwater comparison group, the missing component was a control.

What is the term for the breakdown of glycogen into glucose subunits?
A.
Hydrolysis
B. Reduction
C. Metabolism
D. Transpiration
Rationale
The breakdown of glycogen into glucose subunits is called hydrolysis.
Glycogen is a polysaccharide made of many glucose molecules linked together by glycosidic bonds. To release individual glucose units from this storage molecule, those bonds must be broken. This occurs through a chemical process that involves the use of water, which is characteristic of hydrolysis reactions. In biological systems, specific enzymes catalyze this process so that glucose can be made available for energy production.
A. Hydrolysis
This is the correct answer. Hydrolysis is a reaction in which water is used to break chemical bonds. In glycogen breakdown, the bonds linking glucose units are cleaved so that free glucose (or glucose-1-phosphate, which can be converted to glucose) is released. Although some steps of glycogen breakdown involve phosphate rather than water directly, the overall principle of breaking a polymer into monomers falls under hydrolysis.
B. Reduction
Reduction refers to the gain of electrons or hydrogen atoms in a redox reaction. While glucose may later undergo oxidation during cellular respiration, reduction is not the process used to split glycogen into glucose units.
C. Metabolism
Metabolism is a broad term that includes all chemical reactions in an organism, both anabolic (building) and catabolic (breaking down). Glycogen breakdown is part of metabolism, but "metabolism" is not the specific term for the bond-breaking process itself.
D. Transpiration
Transpiration is a plant process involving the loss of water vapor from leaves through stomata. It has no relationship to glycogen or carbohydrate breakdown.
Conclusion: The specific chemical process used to break glycogen into glucose subunits is hydrolysis, making A the correct answer.

What is required for primary active transport to take place?
A.
Potassium
B. Sodium
C. Glucose
D. Chemical energy
Rationale
Primary active transport requires chemical energy.
Primary active transport is a membrane transport process in which substances are moved across a cell membrane against their concentration or electrochemical gradient. Because this movement goes "uphill," it cannot occur by diffusion and must be powered directly by energy, usually from ATP.
A. Potassium
Potassium ions are commonly moved by primary active transport, especially in the sodium–potassium pump. However, potassium is the substance being transported, not what enables the transport to occur. Its presence is not a requirement for primary active transport in general.
B. Sodium
Sodium ions are also frequently transported by primary active transport, particularly out of the cell by the Naâº/K⺠ATPase. Like potassium, sodium is cargo, not the driving requirement of the process.
C. Glucose
Glucose is usually transported by facilitated diffusion or by secondary active transport (such as sodium–glucose co-transport). It does not directly power primary active transport and is not required for it to take place.
D. Chemical energy
This is the correct answer. Primary active transport depends on chemical energy, almost always supplied by ATP. The transport protein functions as an ATPase, hydrolyzing ATP to ADP and inorganic phosphate. The energy released causes a conformational change in the protein, allowing it to move ions or molecules against their gradient. Without ATP or another chemical energy source, primary active transport cannot occur.
Conclusion
The defining feature of primary active transport is the direct use of chemical energy to move substances against their gradients. Therefore, the correct answer is D. Chemical energy.

_______ is a symbiotic relationship in which one organism benefits and the other is not affected.
A.
Mutualism
B. Parasitism
C. Commensalism
D. Competition
Rationale
Commensalism is a symbiotic relationship in which one organism benefits and the other is not affected.
In biology, symbiosis refers to a close, long-term interaction between two different species. These interactions are classified based on how each organism is affected: positively, negatively, or not at all. Commensalism specifically describes a +/0 relationship, where one organism gains a benefit while the other experiences no significant harm or benefit.
A. Mutualism
Mutualism is a symbiotic relationship in which both organisms benefit (+/+). A classic example is bees and flowering plants: bees obtain nectar for food, while plants benefit from pollination. Since both organisms gain an advantage, this does not match the condition where one organism is unaffected.
B. Parasitism
Parasitism occurs when one organism benefits and the other is harmed (+/−). Parasites such as tapeworms, lice, or disease-causing bacteria gain nutrients or shelter from the host, while the host suffers damage or illness. This clearly differs from a relationship in which the second organism is unaffected.
C. Commensalism
Commensalism is the correct answer. In this type of symbiotic relationship, one organism benefits while the other is neither helped nor harmed (+/0). For example, barnacles attached to a whale gain transportation and access to nutrient-rich waters, while the whale is not significantly affected by their presence. Another example is an orchid growing on a tree for support without harming the tree.
D. Competition
Competition is an interaction where both organisms are negatively affected (−/−) because they are competing for the same limited resources, such as food, space, or light. It is not considered a symbiotic relationship in the classic sense and does not fit the benefit/no-effect pattern.
Conclusion
A symbiotic relationship in which one organism benefits and the other is unaffected is defined as commensalism. Therefore, the correct answer is C. Commensalism.

_______________ is a plant hormone that regulates growth and development.
A.
Tropism
B. Auxin
C. Petiole
D. Chlorophyll
Rationale
Plant hormones are chemical messengers produced in small amounts that control and coordinate growth, development, and responses to stimuli in plants. Auxin is one of the most important and well-studied plant hormones, playing a central role in regulating how plants grow and develop.
A. Tropism
Tropism is not a hormone. It is a growth response of a plant toward or away from an environmental stimulus such as light, gravity, or water. For example, phototropism refers to growth toward light, and gravitropism refers to growth in response to gravity. Tropisms are controlled by hormones like auxin, but they are processes, not chemical regulators themselves.
B. Auxin
Auxin is the correct answer. Auxins are a class of plant hormones, with indole-3-acetic acid (IAA) being the most common natural auxin. Auxin regulates many aspects of plant growth and development, including cell elongation, stem growth, root formation, apical dominance (suppression of side buds), and directional growth responses such as phototropism and gravitropism. By altering cell elongation rates, auxin helps shape the overall form of the plant.
C. Petiole
The petiole is a structural part of the plant. It is the stalk that connects the leaf blade to the stem and helps position the leaf for optimal light exposure. While it is important for leaf support and transport of water and nutrients, it does not function as a hormone or chemical regulator.
D. Chlorophyll
Chlorophyll is a pigment found in the chloroplasts of plant cells. Its role is to absorb light energy for photosynthesis. Chlorophyll is essential for energy capture but does not act as a signaling molecule or regulator of growth and development.
Conclusion
Auxin is a key plant hormone that controls cell elongation, growth patterns, and developmental processes. Therefore, the correct answer is B. Auxin.

How is mitosis different from meiosis?
A.
Mitosis makes sex cells.
B. Meiosis creates cells with half the chromosomes.
C. Telophase doesn't occur in mitosis.
D. Spermatogenesis occurs via mitosis.
Rationale
Meiosis is different from mitosis because it creates cells with half the chromosomes of the parent cell.
Mitosis and meiosis are both forms of cell division, but they serve very different biological purposes. Mitosis is responsible for growth, tissue repair, and maintenance, while meiosis is specialized for sexual reproduction. The key distinction between them is what happens to the chromosome number in the resulting cells.
A. Mitosis makes sex cells
This statement is incorrect. Mitosis produces somatic (body) cells that are genetically identical to the parent cell and to each other. These cells retain the full diploid chromosome number (2n). Sex cells, also called gametes (sperm and eggs), are not produced by mitosis but by meiosis.
B. Meiosis creates cells with half the chromosomes
This is the correct answer. Meiosis is a reduction division. A single diploid parent cell undergoes two consecutive divisions (meiosis I and meiosis II) to produce four haploid daughter cells. Each of these cells contains half the number of chromosomes (n) compared to the parent cell. This reduction is essential so that when fertilization occurs, the resulting zygote restores the normal diploid chromosome number.
C. Telophase doesn't occur in mitosis
This statement is false. Telophase is a normal stage of mitosis, during which nuclear membranes reform around each set of chromosomes and the chromosomes begin to decondense. Telophase also occurs in meiosis, specifically in telophase I and telophase II.
D. Spermatogenesis occurs via mitosis
This statement is misleading and therefore incorrect. Spermatogenesis is the overall process of sperm production. While it begins with mitotic divisions of spermatogonia to maintain the stem cell population, the defining and critical stages of spermatogenesis involve meiosis, which produces haploid sperm cells. Thus, spermatogenesis is characterized by meiosis, not mitosis.
Conclusion
The fundamental difference between mitosis and meiosis is that meiosis reduces the chromosome number by half, producing haploid cells for sexual reproduction, whereas mitosis maintains the chromosome number for growth and repair. Therefore, the correct answer is B.

In Homo sapiens, what does Homo name?
A.
Class
B. Species
C. Genus
D. Family
Rationale
In Homo sapiens, Homo names the genus.
In biological classification, scientific names follow the system of binomial nomenclature, which assigns every species a two-part Latin name. The first word identifies the genus, and the second word identifies the species. This system helps scientists worldwide communicate clearly about organisms and their evolutionary relationships.
A. Class
Class is a higher taxonomic rank than genus. Humans belong to the class Mammalia, which includes all mammals such as whales, bats, and dogs. Since Homo does not represent this level of classification, this option is incorrect.
B. Species
The species name in binomial nomenclature is formed by combining the genus and the specific epithet. In humans, the species is sapiens, not Homo. Therefore, Homo alone does not name the species, making this option incorrect.
C. Genus
Homo is the genus name in Homo sapiens. The genus groups closely related species that share common evolutionary traits, such as Homo erectus and Homo neanderthalensis. Because Homo appears first and is capitalized, it correctly identifies the genus.
D. Family
Family is a broader classification level above genus. Humans belong to the family Hominidae, which includes great apes such as chimpanzees and gorillas. Since Homo is more specific than family, this option is incorrect.
Conclusion
In the scientific name Homo sapiens, Homo identifies the genus, following the rules of binomial nomenclature. Therefore, the correct answer is C. Genus.

HESI A2 Exams
Chemistry Quizzes
3 Practice Tests
Chemistry Quizzes
3 Practice Tests
Anatomy Quizzes
3 Practice Tests
Anatomy Quizzes
3 Practice Tests
Reading Quizzes
4 Practice Tests
Reading Quizzes
4 Practice Tests
Grammar Quizzes
3 Practice Tests
Grammar Quizzes
3 Practice Tests
Vocabulary Quizzes
3 Practice Tests
Vocabulary Quizzes
3 Practice Tests
Physics Quizzes
3 Practice Tests
Physics Quizzes
3 Practice Tests
HESI Quizzes
3 Practice Tests
HESI Quizzes
3 Practice Tests